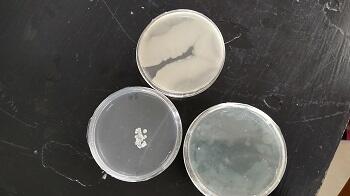

2022年5月の記事一覧
【マリン校舎】旬の果実を缶詰に・・・ びわ缶詰
令和4年5月25日(水)
本日、2・3年生食品系の生徒達は、びわ缶詰の製造実習を行ないました!
原料として使うびわは、天草の鬼池地区で収穫されたもので旬を迎えています。
生徒達は、この実習を通じて天草で獲れる果実について学ぶと共に、果実缶詰を長期保存するためにシロップを酸性にするなど専門的な学習を行なっています。
本日作ったびわ缶詰はマリン祭等で販売予定です。皆さん、見かけたらぜひ召し上がって見てください(^∇^)。
《実習風景》
原料のびわをカゴに入れ、お湯にくぐらせ皮を剥きやすくします
びわの果頂部と果柄部を切り落とし、専用ジグで種と薄皮を取り除いています。
処理したびわを酸性の水溶液につけ、酸化を防止します。
シラップを入れ、封をして完成です!!
【マリン校舎】身の回りの微生物を観察
令和4年5月23日(火)
私たち人間の手や、日常生活を送る部屋には微生物が存在していますが、普通では見ることができません。
そこで、今回2年生食品系の生徒たちは食品管理の授業で標準寒天培地を用いて微生物の培養にチャレンジしました。
まず、自分の手にいる細菌と自分たちが使用する教室にいる空中落下菌を捕まえました。
すると・・・
上の写真の白っぽくなっている部分が微生物が増殖した箇所です(;'∀')
そして、この培養した微生物をスライドガラスに移し、顕微鏡で観察してみました。
スライドガラスに微生物を移しています
顕微鏡で微生物を観察しています
顕微鏡でみた微生物
【マリン校舎】熊本丸2次航海日誌 No.6
令和4年5月21日(土)~令和4年5月23日(月)
熊本丸は現在、東シナ海で順調に調査を行なっています!!
20日(金)は、天候が悪く4箇所調査する予定が1箇所しか調査が行えなかったようです(^_^;)。
しかし、その後は海況も良好で順調に調査を進められているようです。
本日、調査の第1レグが終了し、その後沖縄に向かう予定です。
生徒達は、元気に過ごしているようです!!
《5月21日(土)の実習風景》
調査した緯度・経度を航海記録に記す様子
獲れた魚の選別作業
《5月22日(日)の実習風景》
《5月23日(月)の実習風景》
【マリン校舎】熊本丸2次航海日誌 No.5
令和4年5月18日(水)~令和4年5月20日(金)
熊本丸はこの3日間、東シナ海で調査を行なっています。
昨日までの2日間は、海況も良く問題なく調査を行えていたようです。
しかし、本日は調査海域が時化のため、調査を見合わせているようです(^_^;)
生徒達は元気に、実習に取り組んでいます!!」
《5月18日(水)の実習風景》
レーダで船の周りを見張り中・・・
船での食事も楽しんでいます!!
《5月19日(木)の実習風景》
調査実施中・・・
夜間当直中・・・
《5月20日(金)の実習風景》
司厨員の作業をお手伝いしています!!
当直実施中・・・
調査で獲れた魚
【マリン校舎】食品系缶詰のWeb掲載
令和4年5月18日(水)
一般財団法人 東京水産振興会主催の『水産・海洋高校缶詰瓶詰全国大会』Webサイトに本校食品系が製造した「きびなご味付缶詰」が掲載されています!!
下記のURLより1度ご覧ください!!